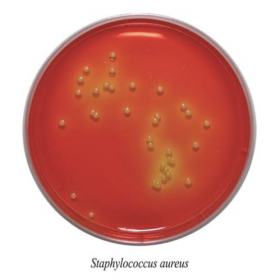
Питательная среда №10 ГРМ (идентификация стафилококков)
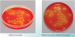
Питательная среда №10 ГРМ (идентификация стафилококков)

Питательная среда №10 ГРМ (идентификация стафилококков)
Питательная среда №10 ГРМ сухая
Для идентификации стафилококков при контроле микробной загрязненности нестерильных лекарственных средств по признаку ферментации маннита, а также при проведении исследований в санитарной и клинической микробиологии.
Данный продукт имеет Регистрационное Удостоверение.
Фасовка 250 г для приготовления 2,1 л среды.
Срок годности 2 года.
- Стерильность: -
- Форма выпуска: Порошок
- Упаковка: 250 г
- Документы: Регистрационное Удостоверение